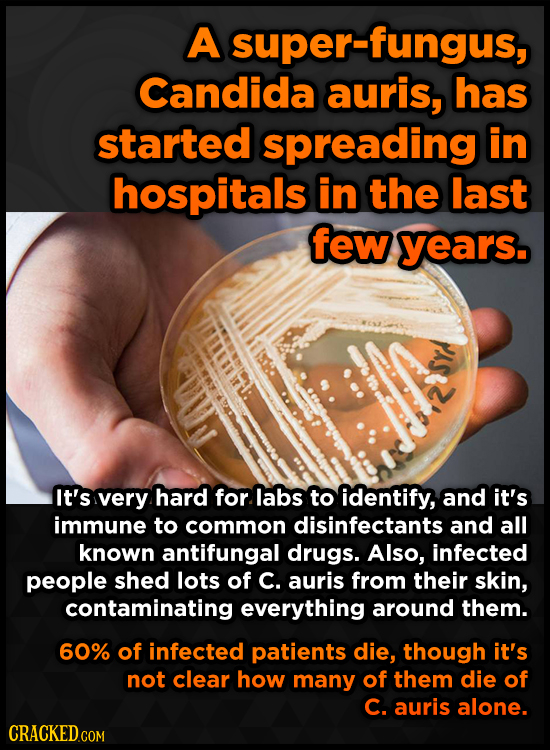
A super-fungus, Candida auris, has started spreading in hospitals in the last few years. It's very hard for labs to identify, and it's immune to commo

22 Horror Movie Moments (That Really Happened)
Tis the season to curl up with your Chucky doll and watch some scary stuff. Maybe keep him at arm's length though and your eyes on that knife.
The thing is, horror movies don't come from nowhere -- they're usually based on some vaguely-similar real-life event, and then cranked up to 11 on the disturb-o-meter and buoyed by some sick John Carpenter keyboard action. So yeah, sometimes real life comes out of the gate with something that's 100 percent horror-movie-level creepy. No cinematography required, just the rights. Here's a compilation ranging from ‘oh yeah that’s weird' to ‘there is no God.’ We're talking about Jesus statues with real human teeth, dudes frozen for ten years in supermarket freezers, razor blades in salads, a chronically running nose that was actually leaky brain fluid.
We aren't kidding here. Even if you're a horror enthusiast, maybe cover Chucky's eyes. We don't want to damage him further.




Router Hacker



Unknown Human Remains

A Raging Cockroach Infestation


The Toothy Tumor



The Knocking
